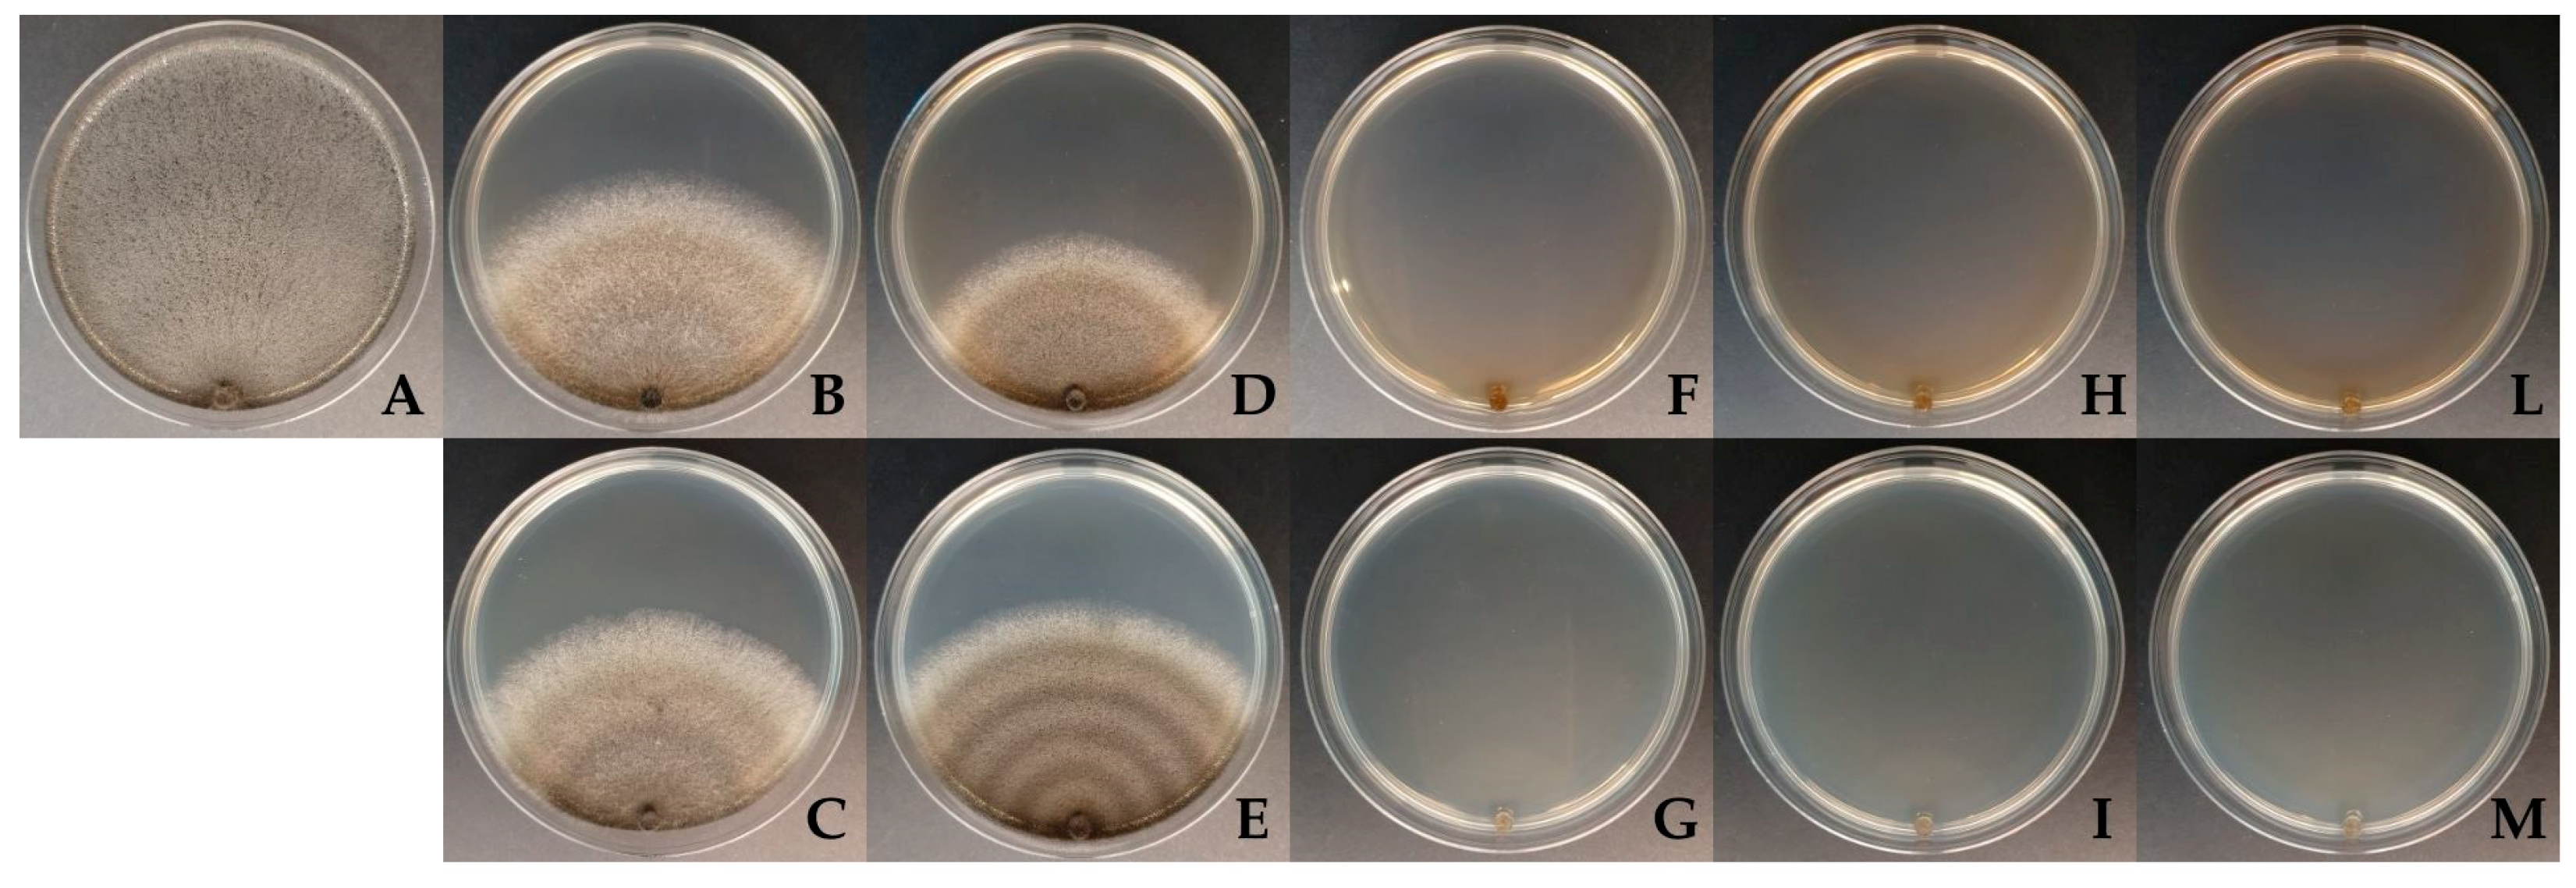
Sustainability 17 00706 g007

1. Introduction
In recent decades, several bio-based products have been studied as potential alternatives to chemicals and pollutants in different sectors, with the aim of preserving human health and the environment. These products are often subject to alterations caused by light, temperature, oxygen and humidity, among other environmental conditions, which can cause their deterioration [
1,
2].
Microencapsulation is a process that improves the stability and preservation of these bioactive compounds by enclosing or coating tiny individual particles or droplets of a solid or liquid substance (the core) in a continuous layer of polymeric material (the shell or coating). There are numerous compounds that can be encapsulated, including bioactive peptides, vitamins, essential oils, caffeine, plant extracts, fatty acids, flavonoids, carotenoids and terpenes, phytotoxins and microbial metabolites. Different types of coating materials such as gums, carbohydrates, proteins, lipids, celluloses and their derivatives and chitosan can be used in the preparation of microcapsules. The microcapsules obtained have dimensions ranging from a few micrometers to a few millimeters. Microcapsules find their applications in many fields, such as the food, cosmetics, medical and pharmaceutical, textile and agricultural industries [
1,
2,
3,
4,
5].
The goal of modern agriculture is to reduce the environmental damage caused by conventional chemicals. With growing interest in biomolecules for use in sustainable agriculture, microencapsulation can be effective for the formulation of biofungicides, biopesticides, bioherbicides and biofertilizers [
6].
The application of new materials derived from woody biomass in agriculture has become a recent necessity in terms of mitigating climate change and increasing carbon sequestration and soil fertility [
7]. Both biochar and wood distillate fit into a circular economy model by using waste woody biomass, reducing reliance on synthetic fertilizers and pesticides and promoting sustainable agricultural practices [
8]. Furthermore, chitosan is one of the most abundant biopolymers on our planet, together with cellulose, and is easily obtainable from chitin-based waste (crustaceans, fungi, insects) using circular economy processes [
9,
10].
Wood distillate (WD) derives from the condensation of pyrolysis gases obtained during the production of biochar from woody biomass and is a dark brown/yellowish liquid with a typical sweet–smoky odor. It consists of over 200 organic compounds of different types and quantities depending on the chemical composition and moisture of the feed biomass and on pyrolysis conditions [
11]. The composition of organic substances includes organic acids, ketones, aldehydes, alcohols, benzene and its derivatives, heterocyclic compounds, phenols and their derivatives, alky phenyl ethers, carbohydrate derivatives and nitrogenous compounds. The pH of WD is always acidic or very acidic, mainly due to the high acetic acid content. Variations in pH can occur both due to the variable composition of the starting woody biomass and due to different amounts of condensation water, which lead to a different dilution of the acid compounds. WD is classified as a corroborant for agricultural use, as it promotes plant growth, improves resistance to pathogens and pests and protects plants from abiotic stresses [
12] (Italian legislation, Presidential Decree 6793 of 18 July 2018).
The application of WD has many beneficial effects on soil properties, enzymes and nutrient availability but is strongly influenced by soil characteristics and the concentration and quantity of product applied. Cardelli et al. found that at high application rates (WD greater than 1% dilution), there was a decrease in most soil enzymatic activities [
13].
However, the application of WD may be limited by the fact that phenols and other active compounds are sensitive to environmental factors such as temperature, light and oxygen [
14,
15], and the smoky and pungent odor of phenolic compounds may cause unpleasant smells [
16]. To overcome this problem, microcapsules can be used to increase the stability and availability of core materials and to protect them from environmental stresses [
17,
18]. In the specific case of WD, encapsulation can also be used to mask unpleasant odors [
19].
Studies have recently been conducted on the encapsulation of some phenolic fractions of WD to improve their stability and availability as well as to preserve their components from environmental factors [
20].
Chitosan is a linear biopolymer consisting of d-glucosamine and N-acetyl-d-glucosamine units linked together by a β (1–4) glycosidic bond [IUPAC name: (1→4)-2-amino-2-deoxy-β-D-glucan]. It is naturally present in the cell wall of some fungi and insects; however, it is produced industrially through the deacetylation of chitin extracted from the exoskeletons of crustaceans. Chitosan is a bioabsorbable and biodegradable compound with antioxidant and antimicrobial properties [
21]. It is used in agriculture to control plant diseases and enhance their defense mechanisms, thanks to its effectiveness against fungi, bacteria and viruses and its ability to stimulate the formation of secondary metabolites [
22].
Biochar is a carbon-rich solid material derived from the pyrolysis of agricultural and forestry residual biomass. In agriculture, biochar is well known for its stability in soil and its ability to increase nutrient bioavailability and crop productivity [
23], and it is commonly applied to soil due its wide range of properties [
24]. Numerous studies have revealed that the use of biochar leads to an increase in microbial biomass but creates significant changes in enzymatic activity and community composition. According to numerous field trials and pot studies, the use of different types of biochar in soils at different rates has been shown to increase the production and growth quality of several plants, including tomato [
25], wheat [
26], bean and maize [
27]. The small particle size of biochar has many well-known advantages, such as increased surface area and reactivity, and the micronization of this biomaterial can increase its potential for use in various sectors.
The aim of this work was to create WD microcapsules coated with chitosan and biochar to preserve and enhance the antifungal activity of WD and chitosan while incorporating the beneficial properties of biochar into the soil. In particular, attention has been paid to the development of a biodegradable and biocompatible product that features the antimicrobial properties of chitosan and its ability to improve plant defense mechanisms [
22], the ability of biochar to increase crop productivity and the availability of nutrients in the soil [
28] and finally the ability to preserve the antifungal and antimicrobial properties of the WD.
To achieve these objectives, the following investigations were carried out: (i) microencapsulation of WD by ionic-exchange gelation and the formation of chitosan and chitosan–biochar coatings; (ii) morphological analysis of the microcapsules through microscopic observations; (iii) evaluation of the in vitro solubilization of microcapsules using pH measurements; and (iv) in vitro growth of Macrophomina phaseolina on semi-solid medium amended with different concentrations of WD and in liquid medium amended with the produced microcapsules.
The valorization of agri-food waste into value-added chemicals could represent a more sustainable and profitable management option and could help meet the global demand for the large-scale reuse of resources and energy. In this context, the availability of WD microcapsules coated with chitosan and biochar could lead to an innovative product that combines the beneficial effects of the three bio-based products and could be a promising tool for sustainable agricultural production and plant protection strategies.
2. Materials and Methods
2.1. Wood Distillate
The wood distillate was produced by Bio-Esperia srl. (Arezzo, Italy) and was obtained from native forest plant species (Abies sp., Alnus sp., Castanea sativa, Fraxinus sp., Quercus sp., Robinia pseudoacacia) with the same physiological water contents by pyro-gasification. The distillation process was characterized by an average temperature of 50–70 °C h−1 over a period of ten hours, with a final peak of 1200 °C for approximately half an hour. The main characteristics of the WD used in this study were as follows: pH 2.8, density 1.037 Kg L−1, TOC 33.8 g L−1, total N 0.43 g L−1, organic acid 32.3 g Kg−1, phenolic compounds 13.0 g L−1 and methanol 13.4 g L−1. Polychlorobiphenyl and polycyclic aromatic hydrocarbon (PAH) contents were determined using solid-phase microextraction prior to their analysis by gas chromatography coupled to tandem mass spectrometry, but none of these toxic compounds were present in relevant concentrations. Among PAHs, only acenaphthylene and phenanthrene reached 0.09 ng L−1, well below the most restrictive legislative limits.
2.2. Microencapsulation Protocol
The ion-exchange gelation method [
29] was used to prepare the wood distillate microcapsules. WD 5% (
v/
v) was added to a 1.5% (
w/
v) sodium alginate (A2033, Sigma-Aldrich, Saint Louis, MO, USA) solution and stirred to obtain a homogeneous solution. The microcapsule production protocol included four steps, as shown in
Figure 1.
1. Microcapsule formation: In this first step, the sodium alginate–WD solution was added dropwise to a 1.5% (w/v) calcium chloride (21115, Sigma-Aldrich, Saint Louis, MO, USA) solution using a blood transfusion set (P.B. Pharma srl, Torino, Italy) and a 0.50 mm diameter hypodermic needle (PIKDARE S.p.A., Como, Italy). The calcium chloride solution was placed on a magnetic stirrer and was gently stirred to prevent the sodium alginate–WD solution from coalescing when the drops were added. After half an hour, the formed WD microcapsules were collected using a sieve.
2. Rinsing with distilled water: Fresh microcapsules were gently stirred in distilled water for 15 min to rinse.
3. Coating formation: Rinsed WD microcapsules were collected from the distilled water using a sieve and then poured into a coating solution with stirring for 30 min. The coating solution consisted of a 1% (w/v) chitosan solution to produce chitosan-coated WD microcapsules or a 1% (w/v) chitosan solution with the addition of micronized biochar at 1% (w/v) to obtain WD microcapsules coated with chitosan and biochar.
4. Drying of microcapsules: Coated or uncoated microcapsules collected using a sieve were allowed to dry for 24 h at room temperature.
Following this protocol, three types of microcapsules were produced: microcapsules containing WD without coating (MWD), microcapsules containing WD coated with chitosan (MWD + C) and microcapsules containing WD coated with chitosan and biochar (MWD + CB). The uncoated WD microcapsules were simply allowed to dry after the rinsing step, skipping the coating step.
2.3. Chitosan Coating
A preliminary test was conducted to determine if a consistent coating of chitosan would form around the microcapsules. For this experiment, we prepared a solution of 1% (w/v) chitosan (448869, Sigma-Aldrich, Saint Louis, MO, USA) in 1% (v/v) glacial acetic acid (CARLO ERBA Reagents srl, Milan, Italy). This solution was stained with acid fuchsin (F8129, Sigma-Aldrich, Saint Louis, MO, USA, 1 mg mL−1) to allow for the observation of proper coating formation. Fresh WD microcapsules, already rinsed in distilled water, were poured into the stained chitosan solution and stirred for 30 min to allow the coating to form. Subsequently, the microcapsules were recovered through a sieve and left to dry for 24 h.
Following this preliminary test, the formation of the chitosan coating around the WD microcapsules was carried out with the same steps described above.
2.4. Chitosan and Micronized Biochar Coating
Micronized biochar 1% (w/v) was added to a chitosan solution prepared as previously described in 50 mL Falcon tubes. The tubes were placed in a Multi RS-60 programmable rotator (Biosan, Riga, Latvia) for 24 h to uniformly suspend the micronized biochar. The rotator scheme was as follows: orbital 60 rpm/20 s, reciprocal 90°/30 s, vibro 3°/5 s. Fresh microcapsules containing WD (previously rinsed in distilled water) were added to the chitosan–biochar suspension and gently stirred for 30 min to create a chitosan–biochar coating around the microcapsules. They were subsequently collected through a sieve and left to dry for 24 h at room temperature.
2.5. Characterization of Microcapsules
2.5.1. Weight and WD Amount
The weight of 150 microcapsules of each type (MWD, MWD + C and MWD + CB) was measured. The microcapsules were weighed first fresh and then dry, and the experiment was repeated three times. In this way, we were able to calculate the weight of a single dried microcapsule and determine how much it decreased over a day during the drying process.
Furthermore, the number of drops of sodium alginate–WD solution needed to reach the volume of 1 mL was counted, and the experiment was repeated three times. With this information, we were able to calculate the WD volume contained in each drop, which corresponded to the amount of WD contained in each microcapsule.
2.5.2. WD Loss During Production
During the formation of the microcapsules, we noticed a slight change in the color of the calcium chloride solution, which led us to infer a loss of WD during this step.
To estimate WD loss, sodium alginate–WD solution was added dropwise to 50 mL of calcium chloride solution for 30 min. The formed microcapsules were then removed using a sieve, and the pH of the calcium chloride solution was measured with a PH 7 portable pH meter (XS Instruments, Modena, Italy).
WD was then added dropwise to 50 mL of calcium chloride solution, stopping when the pH of the mixture reached the pH of the solution used to form the microcapsules. The experiment was performed in triplicate. We were thus able to estimate the amount of WD present in the calcium chloride solution.
To determine the amount of sodium alginate–WD solution used in a given time, we calculated the number of microcapsules generated in 20 min. By knowing the amount of WD dispersed and the volume of sodium alginate–WD solution used, it was possible to estimate the percentage of WD loss during the production of the microcapsules.
2.5.3. Morphological Analysis
The WD microcapsules, both with and without the different coatings, were observed with a Leica MZ FLIII stereomicroscope (Leica Microsystems Ltd., Heerbrugg, Switzerland). Images were captured using a Leica DFC 450C digital microscope camera with LASX Version 3.1.1.17751 control software (Leica Microsystems Ltd., Heerbrugg, Switzerland), and the diameter of fresh and dried microcapsules was measured (n = 150).
2.5.4. Solubilization
We hypothesized that the solubilization of the microcapsules was related to the pH difference measured during the experiment.
The microcapsules were placed in 5 mL of sterile distilled water in a 15 mL Falcon tube. A specific amount of each type of microcapsule (MWD 0.041 g, MWD + C 0.042 g and MWD + CB 0.047 g) was used to achieve a WD concentration of 3%. The experiment was performed in triplicate, and three tubes with 5 mL of sterile distilled water without microcapsules were used as control. The tubes were placed in a Multi RS-60 programmable rotator (Biosan, Riga, Latvia) for 4 days with the following program: orbital 60 rpm/20 s, reciprocal 90°/30 s. The pH of the solution was measured at the end of the experiment using a PH 7 portable pH meter (XS Instruments, Modena, Italy).
2.6. Fungal Culture Conditions
The soil-borne fungal pathogen used in this study was
Macrophomina phaseolina (DAFE 10726) [
30], which was grown on Petri plates containing PDA culture medium (42 g L
−1 Potato Dextrose Agar, Biolife Italiana srlsrl, Milano, Italy) at 25 °C with a 12/12 NUV/light cycle. The fungus was periodically transferred to new PDA Petri plates to keep the mycelium actively growing.
2.7. Antifungal Activity of WD In Vitro
The WD was filtered using 0.22 µm syringe filters to sterilize it and remove any solid residues. The pH of WD was measured with a PH 7 Portable pH Meter (XS Instruments, Modena, Italy).
To evaluate the antifungal activity of WD, PDA Petri plates were prepared with various amounts of WD (1, 2, 3, 4 and 5%; PDA + WD). The PDA was sterilized at 121 °C for 20 min, and WD was added when the temperature of the medium dropped below 50 °C. The pH of the medium at each WD concentration was measured as the medium solidified using a flat-surface pH electrode (Hanna Instruments Inc., Woonsocket, RI, USA).
As a control, PDA Petri plates modified with glacial acetic acid (CARLO ERBA Reagents srl, Milan, Italy) were prepared. Sterilized PDA was mixed with varying amounts of acetic acid at a warm temperature to create a medium (PDA + AA) that had a modified pH as close as possible to the pH of each concentration of PDA + WD (1% = pH 4.34; 2% = pH 4.09; 3% = pH 3.94; 4% = pH 3.84; and 5% = pH 3.76).
As an additional control, buffered PDA Petri plates were also prepared using 0.1 M MES buffer solution (69892, Sigma-Aldrich Co., St. Louis, MO, USA) (PDA MES). The medium was sterilized at 121 °C for 20 min, and WD (1, 2 and 3%) was added when the medium temperature dropped below 50 °C. The pH of the medium was adjusted to 5.5 using 1 M NaOH to mimic the pH of PDA.
Mycelial discs (6 mm Ø) were cut from the edge of actively growing M. phaseolina colonies and inoculated onto the edge of PDA + WD, PDA + AA and PDA Petri plates. Three replicates were performed for each treatment. The plates were incubated at 25 °C with a 12/12 NUV/light cycle, and mycelial growth measurements were taken every 24 h until the mycelia in all PDA control replicates reached the opposite edge of the Petri plate, which occurred 96 h after inoculation.
2.8. Antifungal Activity of Microcapsules In Vitro
The efficacy of the three types of microcapsules against M. phaseolina was evaluated in YMB liquid medium with the following composition (g L−1): yeast extract 3 (Biolife Italiana srl, Milan, Italy), malt extract 3 (Biolife Italiana srl, Milan, Italy), bacteriological peptone 5 (Biolife Italiana srl, Milan, Italy), anhydrous glucose 10 (Carlo Erba Reagents srl, Milan, Italy). The microcapsules produced were not sterile, so we added streptomycin sulfate 0.3 g L−1 (S9137, Sigma-Aldrich Co., St. Louis, MO, USA) to the YMB medium (YMB + S) to reduce the amount of contamination during experiments.
A specific amount of each type of microcapsule (MWD 0.232 g, MWD + C 0.236 g, MWD + CB 0.261 g) was added to 50 mL Falcon tubes containing 28 mL of YMB+ S medium to achieve a WD concentration of 3%. All tubes were incubated in a Thermolyne ROSI 1000 reciprocating/orbital shaking incubator (International P.B.I. S.p.A., Milan, Italy) at 125 rpm and room temperature for 4 days to allow the microcapsules to begin to solubilize.
After 4 days, all contents of the tubes were vacuum filtered using Whatman No.1 filter paper to separate the culture medium from the microcapsules. The filtered media were sterilized by filtration using sterile 0.22 µm syringe filters and placed in 50 mL Falcon tubes. The tubes were then inoculated with five mycelium discs (6 mm Ø) cut from the edge of actively growing colonies of M. phaseolina and incubated for 10 days as described before. At the end of incubation period, the fungal mycelium was recovered by vacuum filtration using Whatman No.1 filter paper, and its fresh weight was recorded.
The experiment was performed in triplicate, and three tubes with 28 mL of YMB+S medium without microcapsules were used as control.
2.9. Statistical Analysis
All data were subjected to a completely randomized one-way analysis of variance (ANOVA), and means were separated by Tukey’s HSD test (for
p ≤ 0.05 or
p ≤ 0.01) using the statistical program CoStat 6.4 (Cohort Software, Monterey, CA, USA). The normality of the data was tested using the D’Agostino–Pearson test (for
p ≤ 0.05) using the CoStat 6.4 statistical program. The distributions of microcapsule size data were plotted graphically using Past 4.03 statistical software [
31].
4. Discussion
In this work, the microencapsulation of wood distillate (WD) by ion-exchange gelation using sodium alginate and calcium chloride and the formation of a chitosan or chitosan–biochar coating were successfully achieved.
The ion-exchange gelation method using sodium alginate and calcium chloride has been widely applied in the production of microcapsules in various industrial fields [
32,
33,
34]. Recently, three major phenolic fractions were extracted from WD. To improve the stability of WD extracts and facilitate their preservation, they were encapsulated for the first time, using alginate, chitosan and the ionic gelation method [
20].
Sodium alginate solutions experience significant changes in viscosity in acidic environments, as the introduction of acids can destroy the molecular structure of the alginate, leading to a reduction in its viscosity [
35]. Therefore, in this study, only 5% (
v/
v) WD was added to the sodium alginate solution to produce the microcapsules in order to minimize the impact on its viscosity.
Conventionally, microcapsules have a size between 1 and 1000 µm, while those larger than 1000 µm are classified as capsules [
36]. Zheng et al. reported that alginate microcapsules are often relatively large, with a typical size range of 150 µm to 800 µm [
37].
The diameter of all dried microcapsules produced in this work measured between 600 µm and 700 µm, which is within the ranges described by other studies. The size of the microcapsules followed a normal distribution, and their coating was uniformly distributed on their surface. A significant reduction in weight and size was observed between the fresh and dried microcapsules, particularly in those without coating. The coating also served to preserve the regular shape of the microcapsules during the drying process. The simplicity of the protocol for the production of microcapsules, its cost effectiveness and the use of materials from circular economy practices make the process sustainable, practical and accessible.
The WD microcapsules produced in this study are intended for use in conventional and organic agriculture to improve soil characteristics and plant defense against fungal pathogens. To evaluate their effectiveness, solubilization tests were conducted by measuring the pH of each type of microcapsule in distilled water. Several mechanisms used to release the core material of the microcapsules have been described, and one of these is the change in pH [
1].
Assuming that the pH change is caused by the solubilization of specific components of the microcapsules, the rapid lowering of the pH of solutions containing MWD could be caused by the release of WD due to lack of coating. In the case of solutions containing MWD + CB, an increase in pH occurred due to the release of micronized biochar from the coating (the pH of an aqueous suspension of micronized biochar is greater than 10.0). After 4 days, significant statistical differences were observed in the solubilization of all microcapsules, indicating the successful release of their components.
Results from the in vitro growth assay of the fungal pathogen M. phaseolina clearly highlighted the antifungal activity of WD, with complete growth inhibition observed at WD concentrations of 3%.
Our results are in line with those of Borines et al., who evaluated 11 different wood distillates in vitro against the fungal pathogen
Sclerotium rolfsii, known to cause sclerotium wilt in tomato. In their work, four concentrations (0.2, 0.5, 1 and 2%) of WD were added to PDA. A WD concentration of 2% inhibited the growth of
S. rolfsii, while doses lower than 1% showed no inhibition against the pathogen [
38].
In another study, Chuaboon et al. achieved growth inhibition rates greater than 70% using a 5% concentration of bamboo WD against the fungal pathogens
Alternaria padwickii,
Curvularia lunata,
Fusarium semitectum and
Bipolaris oryzae [
39].
Different concentrations of guava WD (0, 0.25, 0.50, 1, 2 and 3%) were tested to evaluate the growth inhibition of
Colletotrichum coccodes. The maximum inhibition (100%) of the causal agent of potato black dot disease was achieved with 3% guava WD [
40].
According to these and many other studies, the antifungal activity of WD depends on the susceptibility of the pathogens and the woody biomass from which it derives. However, in many circumstances, effectiveness has been demonstrated by adding concentrations of 1 to 5% WD to growth medium such as PDA.
The antifungal activity of WD was found to be relevant even when its acidic pH was buffered with MES and neutralized to reach the pH of PDA (5.5). Our results lead to the conclusion that the low pH of WD is an important but not exclusive factor for its antifungal activity and that other components also play a role against the tested fungal pathogen.
Suresh et al. tested native WD with an acidic pH (pH 3.7) and neutralized WD (pH 7.0) in vitro against fungi known to cause wood rot and food contamination, such as
Trametes versicolor,
Aspergillus niger and
A. fumigatus. Their data demonstrated that acidic WD was more effective than neutralized WD on all fungal strains. This difference in efficacy may be the result of a change in the ionization of the phenolic contents of the neutralized WD, since phenolics have antioxidant characteristics that inhibit fungal growth [
41].
Over the past 10 years, research on WD has increased considerably, indicating that this product may represent a viable alternative for managing plant disease and promoting plant growth. However, there are very few data involving the production of WD-based microcapsules. For this reason, further research will be necessary to evaluate their efficacy both in the greenhouse and in the field to confirm their potential application as products for sustainable agriculture.
5. Conclusions
The results of this study showed that the ion-exchange gelation method using sodium alginate as the polymer is a suitable method for entrapping WD with high encapsulation efficiency. Furthermore, the formation of a coating consisting of chitosan and biochar showed significant in vitro efficacy against the soil-borne pathogenic fungus Macrophomina phaseolina.
The combined use of WD, micronized biochar and chitosan can improve their effectiveness compared to their separate use for the control of seed- and soil-borne fungal pathogens. These three compounds are part of a sustainable path toward a circular economy. Therefore, the production of microcapsules made of these materials, all biodegradable and biocompatible, can bring benefits in terms of preserving the properties of WD. Added to this important aspect are the advantageous effects of chitosan and biochar on the environment, on the control of plant diseases and on agricultural productivity.
There is no information in the literature on the integrated use of WD, micronized biochar and chitosan for the protection of plants against seed- and soil-borne pathogens. Furthermore, we believe that WD-containing alginate microcapsules with micronized biochar and chitosan as an outer shell are a formulation not yet studied for sustainable agriculture and crop protection and may represent a valid alternative to conventional agrochemicals.